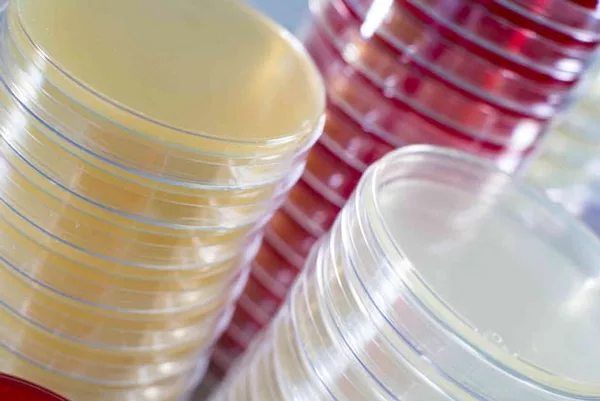

Lab M’s Products are Now Compliant with ISO 11133:2014
Lab M’s products are now compliant with the latest industry standards to ensure customers can always rely on high quality results and batch-to-batch media consistency. Since March 2015, Lab M has been compliant according to ISO 11133:2014 which relates to the microbiology of food, animal feed and water--culture media preparation, production, storage and testing. In addition, the quality control laboratory at Lab M is working towards ISO 17025, with United Kingdom Accreditation Service accreditation anticipated in the coming months.
The new ISO 11133:2014 standard was published in May 2014 and replaces the previous standards EN ISO TS 11133-1:2009 and EN ISO TS 11133-2:2003 which separately covered preparation of culture media and performance testing of culture media. The ISO 11133:2014 standard applies to all types of media formulation, including dehydrated culture media (DCM) and ready-prepared media that are used for all applications – whether these are conventional culture or rapid methods. Each batch of Lab M media is appropriately tested using the specific test strain named in the standard. ISO 11133:2014 ensures the improvement to consumer safety in food and beverage products and that performance should imitate the intended sample testing conditions.
Lab M is also working towards ISO 17025 to demonstrate compliance with the relevant standard for the quality control testing of Pinnacle™ pre-poured plates, using the company’s own DCM. This includes the extension of the existing quality management system for quality control testing and adherence to rigorous technical requirements. Customers will benefit from peace of mind that Pinnacle™ plates can be relied on without the need to perform any supplementary QC tests of their own.
“Lab M is very proud of its heritage of producing high quality microbiological products. By adopting these standards, Lab M further validates its commitment to continual development and improvement,” says Lyn Richards, Lab M’s quality assurance and regulatory affairs manager. “Customers can have peace of mind that they can rely on Lab M for accurate, fast, reliable results and batch-to-batch media consistency.”
Lab M has produced a white paper on the new International Standard ISO 11133:2014 detailing the requirements of the standard and explaining the steps taken by Lab M to ensure compliance. To request a copy, email whitepapers@labm.com.
Looking for quick answers on food safety topics?
Try Ask FSM, our new smart AI search tool.
Ask FSM →








